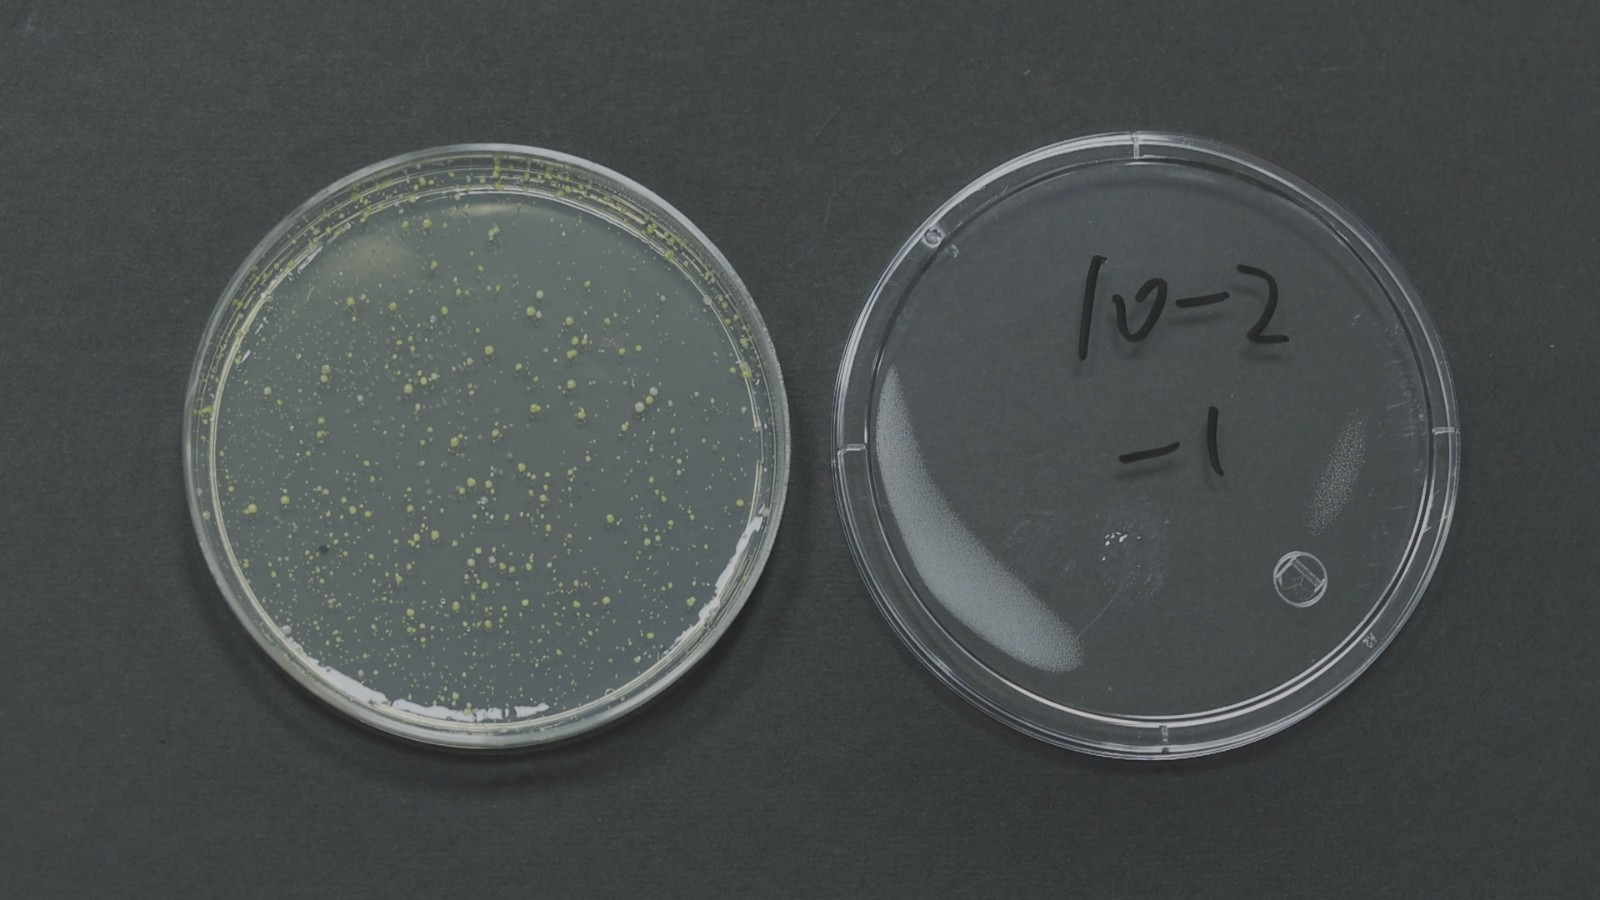

12月8日 周一21:38锁定北京卫视《我是大医生》,领取冬季护肤全套攻略吧!

一到冬天,寒冷、干燥等环境状况给我们的皮肤带来一系列健康隐患,生活中的一些小细节不注意,就会在这个冬季给衰老按下了加速键!
《我是大医生》特邀北京大学第一医院副院长李航,带来冬季护肤全套攻略,不花一分钱,自制秘制保湿洗脸水;每天5分钟,锻炼脸部去皱操。更有场内场外实验实测,为你评测冬季好物,不花冤枉钱,护肤全方位!


现场实测大医生秘制洗脸水,保湿效果超加倍!
冬季皮肤干燥是绝大多数人的困扰,面部皮肤保湿不及时会导致我们出现皮屑、黄斑、痘印、皱纹,看上去迅速衰老!
家家都有的一种粉末,制成保湿水洗脸洗全身。医生梦之队现场检验,分别用清水、秘制洗脸水洗手臂五分钟,清洗后模拟冬季冷风立即吹干,对比前后皮肤水分含量。
两位使用了秘制洗脸水的主持团成员,林医生皮肤水分含量从使用前的23%升高到了29%,优优从15%升高到了22%,而使用清水洗手臂的两位主持人皮肤含水量没有任何变化!



这种家家必备的白色粉末就是我们厨房常用的淀粉,用薄薄的淀粉水洗脸洗手后,在皮肤表面形成一层锁水膜,有效保湿!李航院长现场演示自制过程,具体如何配比,今晚揭晓!

技能去皱操,在传统的护肤中加入这些技能!
70岁护肤达人有着40岁皮肤状态,卢阿姨从2018年起,研究面部去皱操,锻炼脸部肌肉辅助预防、延缓面部皮肤松散衰老。

去皱操有三个动作,分别针对颈纹、法令纹、抬头纹,锻炼相关肌肉,让肌肉充实饱满更好地支撑面部,防垮脸!


你可能在用致病菌擦脸,毛巾使用情况大调查!
我们选取了10户人家的毛巾,进行了细菌培养,其中半数的毛巾均培养出了细菌菌落。毛巾材质网状结构、空隙结构较多,又通常被放置在潮湿的洗手间等位置,有利于细菌的滋生。毛巾擦脸,皮肤脱落的蛋白质又成为了细菌丰盛的口粮。

李航院长建议每天使用毛巾后投洗干净,每周进行晾晒,每月进行水煮杀菌,3到6个月最好更换一条毛巾。

冬季接受到的紫外线可能更强,不防晒老得快!
夏季炎热潮湿,冬季寒冷干燥,而环境中的紫外线强度与温度无关,却因湿度降低反而强度更高。大医生现场实证,用烘干机模拟冬季干燥,加湿器模拟夏季潮湿,肉眼可见在干燥环境下,人体接受到的紫外线强于潮湿环境!

李航院长建议大家冬季防晒,以物理防晒为主,衣物遮挡住的部位,可以有效降低被紫外线照射的程度。长时间在户外或玻璃窗边活动,没有衣物遮挡的皮肤部位还是需要涂上防晒霜。

应对冬季皮肤问题,保湿、抗衰、防晒,三步缺一不可,跟随院长的护肤指导,让一整个冬天水水嫩嫩,颜面不老,皮肤更健康!周一21:38锁定北京卫视《我是大医生》,领取冬季护肤全套攻略吧!
特别鸣谢:



